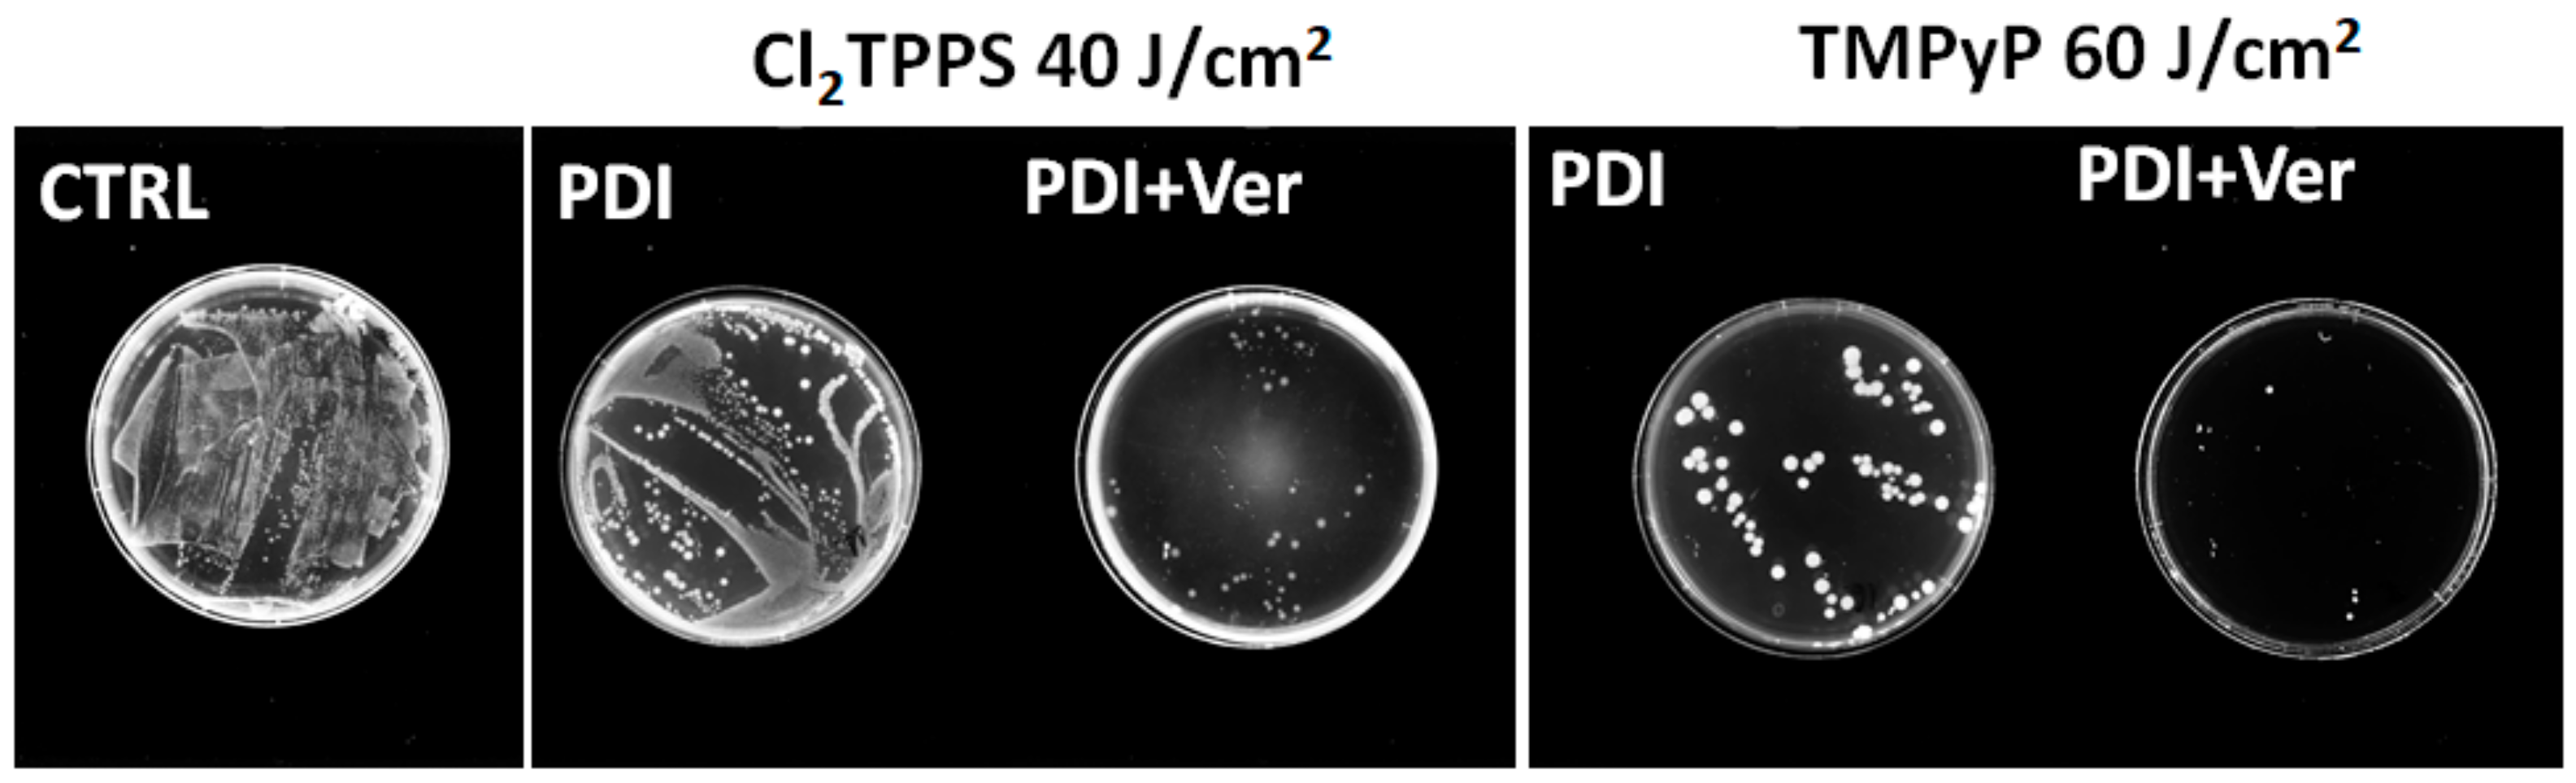
Ijms 21 08716 g017

Photodynamic Inactivation of Bacteria with Porphyrin Derivatives: Effect of Charge, Lipophilicity, ROS Generation, and Cellular Uptake on Their Biological Activity In Vitro
Abstract
1. Introduction
2. Results
2.1. Photosensitizers
2.2. Spectroscopic Characterization of the Photosensitizers
2.3. Theoretical Calculations
2.4. Cyclic Voltammetry
2.5. Mechanistic Studies
2.5.1. Singlet Oxygen Quantum Yields
2.5.2. Photoactivity of Photosensitizers
2.6. Photostability of the Photosensitizers
2.7. Determination of Partition Coefficients (LogP)
2.8. The Accumulation of Photosensitizers into Bacteria Cells
2.9. Photodynamic Inactivation of Microorganisms
2.10. MDR Activity
3. Discussion
4. Materials and Methods
4.1. Physicochemical Properties
4.1.1. Chemicals
4.1.2. UV-Vis-NIR Electronic Absorption Spectra Measurements
4.1.3. Photostability Tests
4.1.4. Emission Spectra and Fluorescence Quantum Yield
4.1.5. Fluorescence Lifetime Measurements
4.1.6. LogP Determination
4.2. Mechanistic Studies
4.2.1. Detection of Singlet Oxygen with DMA
4.2.2. Detection of Reactive Oxygen Species (ROS) with Fluorescent Probes
4.2.3. Iodine Starch Test
4.2.4. Theoretical Calculations
4.2.5. Cyclic Voltammetry and Spectroelectrochemistry Measurements
4.3. Biological Studies
4.3.1. Bacterial Strains and Culture Conditions
4.3.2. Binding of the Photosensitizer to Microorganisms—Uptake Studies
4.3.3. ROS Generation In Vitro
4.3.4. Laser Scanning Confocal Microscopy (LSCM) Imaging
4.3.5. Efflux Pump Activity—MDR Resistance Assay
4.3.6. Photoinactivation of the Microorganisms (PDI)
4.3.7. Scanning Electron Microscopy (SEM) Imaging
4.3.8. Statistical Analysis
5. Conclusions
Supplementary Materials
Author Contributions
Funding
Conflicts of Interest
Abbreviations
| ABC | ATP-binding cassette |
| CFU | Colony forming unit |
| DFT | Density functional theory |
| DMMB | 1,9-dimethylmethylene blue |
| DNA | Deoxyribonucleic acid |
| EPI | Efflux pump inhibitor |
| HOMO | Highest occupied molecular orbital |
| ISC | Intersystem crossing process |
| LUMO | Lowest unoccupied molecular orbital |
| LPS | Lipopolysaccharides |
| MB | Methylene blue |
| MDR | Multidrug resistance |
| MEP | Microbial efflux pump |
| NHE | Normal hydrogen electrode |
| NSC | Normal standard electrode |
| PDI | Photodynamic inactivation |
| PDT | Photodynamic therapy |
| PS | Photosensitizer |
| RB | Rose Bengal |
| ROS | Reactive oxygen species |
| SAR | Structure–activity relationship |
| SCE | Saturated calomel electrode |
| TBO | Toluidine blue O |
| TDDFT | Time-dependent density functional theory |
References
- Kuciauskas, D.; Lin, S.; Seely, G.R.; Moore, A.L.; Moore, A.T.A.; Gust, D.; And, T.D.; Reed, C.A.; Boyd, P.D.W. Energy and Photoinduced Electron Transfer in Porphyrin−Fullerene Dyads. J. Phys. Chem. 1996, 100, 15926–15932. [Google Scholar] [CrossRef]
- Jeong, Y.J.; Kang, Y.; Han, A.-R.; Lee, Y.-M.; Kotani, H.; Fukuzumi, S.; Nam, W. Hydrogen Atom Abstraction and Hydride Transfer Reactions by Iron(IV)-Oxo Porphyrins. Angew. Chem. Int. Ed. 2008, 47, 7321–7324. [Google Scholar] [CrossRef] [PubMed]
- Grinstaff, M.W.; Hill, M.G.A.; Labinger, J.; Gray, H.B. Mechanism of catalytic oxygenation of alkanes by halogenated iron porphyrins. Science 1994, 264, 1311–1313. [Google Scholar] [CrossRef] [PubMed]
- Wiehe, A.; O’Brien, J.M.; Senge, M.O. Trends and targets in antiviral phototherapy. Photochem. Photobiol. Science 2019, 18, 2565–2612. [Google Scholar] [CrossRef] [PubMed]
- De Freitas, L.M.; Lorenzón, E.N.; Santos-Filho, N.A.; Zago, L.H.D.P.; Uliana, M.P.; De Oliveira, K.T.; Cilli, E.M.; Fontana, C.R. Antimicrobial Photodynamic therapy enhanced by the peptide aurein 1.2. Sci. Rep. 2018, 8, 1–15. [Google Scholar] [CrossRef] [PubMed]
- Paszko, E.; Ehrhardt, C.; Senge, M.O.; Kelleher, D.P.; Reynolds, J.V. Nanodrug applications in photodynamic therapy. Photodiagnosis Photodyn. Ther. 2011, 8, 14–29. [Google Scholar] [CrossRef]
- Dąbrowski, J.M.; Pucelik, B.; Regiel-Futyra, A.; Brindell, M.; Mazuryk, O.; Kyzioł, A.; Stochel, G.; Macyk, W.; Arnaut, L.G. Engineering of relevant photodynamic processes through structural modifications of metallotetrapyrrolic photosensitizers. Coord. Chem. Rev. 2016, 325, 67–101. [Google Scholar] [CrossRef]
- Plaetzer, K.; Krammer, B.; Berlanda, J.; Berr, F.; Kiesslich, T. Photophysics and photochemistry of photodynamic therapy: Fundamental aspects. Lasers Med Sci. 2009, 24, 259–268. [Google Scholar] [CrossRef]
- Dąbrowski, J.M.; Arnaut, L.G. Photodynamic therapy (PDT) of cancer: From local to systemic treatment. Photochem. Photobiol. Sci. 2015, 14, 1765–1780. [Google Scholar] [CrossRef]
- Kuncewicz, J.; Dąbrowski, J.M.; Kyzioł, A.; Brindell, M.; Łabuz, P.; Mazuryk, O.; Macyk, W.; Stochel, G. Perspectives of molecular and nanostructured systems with d- and f-block metals in photogeneration of reactive oxygen species for medical strategies. Coord. Chem. Rev. 2019, 398, 113012. [Google Scholar] [CrossRef]
- Pucelik, B.; Sułek, A.; Barzowska, A.; Dąbrowski, J.M. Recent advances in strategies for overcoming hypoxia in photodynamic therapy of cancer. Cancer Lett. 2020, 492, 116–135. [Google Scholar] [CrossRef] [PubMed]
- Pucelik, B.; Sułek, A.; Dąbrowski, J.M. Bacteriochlorins and their metal complexes as NIR-absorbing photosensitizers: Properties, mechanisms, and applications. Coord. Chem. Rev. 2020, 416, 213340. [Google Scholar] [CrossRef]
- Dąbrowski, J.M. Reactive Oxygen Species in Photodynamic Therapy: Mechanisms of Their Generation and Potentiation. Adv. Inorg. Chem. 2017, 70, 343–394. [Google Scholar] [CrossRef]
- Dąbrowski, J.M.; Arnaut, L.G.; Pereira, M.M.; Urbanska, K.; Simões, S.; Stochel, G.; Cortes, L. Combined effects of singlet oxygen and hydroxyl radical in photodynamic therapy with photostable bacteriochlorins: Evidence from intracellular fluorescence and increased photodynamic efficacy in vitro. Free. Radic. Biol. Med. 2012, 52, 1188–1200. [Google Scholar] [CrossRef] [PubMed]
- Staroń, J.; Dąbrowski, J.M.; Cichoń, E.; Guzik, M. Lactose esters: Synthesis and biotechnological applications. Crit. Rev. Biotechnol. 2017, 38, 245–258. [Google Scholar] [CrossRef] [PubMed]
- Pucelik, B.; Paczyński, R.; Dubin, G.; Pereira, M.M.; Arnaut, L.G.; Dąbrowski, J.M. Properties of halogenated and sulfonated porphyrins relevant for the selection of photosensitizers in anticancer and antimicrobial therapies. PLoS ONE 2017, 12, e0185984. [Google Scholar] [CrossRef]
- Arnaut, L.G.; Pereira, M.M.; Dąbrowski, J.M.; Silva, E.F.F.; Schaberle, F.A.; Abreu, A.R.; Rocha, L.B.; Barsan, M.M.; Urbańska, K.; Stochel, G.; et al. Photodynamic Therapy Efficacy Enhanced by Dynamics: The Role of Charge Transfer and Photostability in the Selection of Photosensitizers. Chem. A Eur. J. 2014, 20, 5346–5357. [Google Scholar] [CrossRef]
- Dąbrowski, J.M.; Arnaut, L.G.; Pereira, M.M.; Monteiro, C.J.; Urbańska, K.; Simões, S.; Stochel, G. New Halogenated Water-Soluble Chlorin and Bacteriochlorin as Photostable PDT Sensitizers: Synthesis, Spectroscopy, Photophysics, and in vitro Photosensitizing Efficacy. Chem. Med. Chem. 2010, 5, 1770–1780. [Google Scholar] [CrossRef]
- Dąbrowski, J.M.; Pereira, M.M.; Arnaut, L.G.; Monteiro, C.J.P.; Peixoto, A.F.; Karocki, A.; Urbanska, K.; Stochel, G. Synthesis, Photophysical Studies and Anticancer Activity of a New Halogenated Water-Soluble Porphyrin. Photochem. Photobiol. 2007, 83, 897–903. [Google Scholar] [CrossRef]
- Dąbrowski, J.M.; Pucelik, B.; Pereira, M.M.; Arnaut, L.G.; Stochel, G. Towards tuning PDT relevant photosensitizer properties: Comparative study for the free and Zn2+ coordinated meso-tetrakis[2,6-difluoro-5-(N-methylsulfamylo)phenyl]porphyrin. J. Coord. Chem. 2015, 68, 3116–3134. [Google Scholar] [CrossRef]
- Supur, M.; Fukuzumi, S. Photodriven Electron Transport within the Columnar Perylenediimide Nanostructures Self-Assembled with Sulfonated Porphyrins in Water. J. Phys. Chem. C 2012, 116, 23274–23282. [Google Scholar] [CrossRef]
- Sułek, A.; Pucelik, B.; Kuncewicz, J.; Dubin, G.; Dąbrowski, J.M. Sensitization of TiO2 by halogenated porphyrin derivatives for visible light biomedical and environmental photocatalysis. Catal. Today 2019, 335, 538–549. [Google Scholar] [CrossRef]
- Cieplik, F.; Deng, D.; Crielaard, W.; Buchalla, W.; Hellwig, E.; Al-Ahmad, A.; Maisch, T. Antimicrobial photodynamic therapy – what we know and what we don’t. Crit. Rev. Microbiol. 2018, 44, 571–589. [Google Scholar] [CrossRef] [PubMed]
- Hamblin, M.R.; Hasan, T. Photodynamic therapy: A new antimicrobial approach to infectious disease? Photochem. Photobiol. Sci. 2004, 3, 436–450. [Google Scholar] [CrossRef]
- Giusti, J.S.M.; Santos-Pinto, L.; Pizzolito, A.C.; Helmerson, K.; Carvalho-Filho, E.; Kurachi, C.; Bagnato, V.S. Antimicrobial Photodynamic Action on Dentin Using a Light-Emitting Diode Light Source. Photomed. Laser Surg. 2008, 26, 281–287. [Google Scholar] [CrossRef]
- Maliszewska, I.; Leśniewska, A.; Olesiak-Banska, J.; Matczyszyn, K.; Samoć, M. Biogenic gold nanoparticles enhance methylene blue-induced phototoxic effect on Staphylococcus epidermidis. J. Nanoparticle Res. 2014, 16, 1–16. [Google Scholar] [CrossRef]
- Konopka, K.; Goslinski, T. Photodynamic Therapy in Dentistry. J. Dent. Res. 2007, 86, 694–707. [Google Scholar] [CrossRef]
- Regiel-Futyra, A.; Dąbrowski, J.M.; Mazuryk, O.; Śpiewak, K.; Kyzioł, A.; Pucelik, B.; Brindell, M.; Stochel, G. Bioinorganic antimicrobial strategies in the resistance era. Coord. Chem. Rev. 2017, 351, 76–117. [Google Scholar] [CrossRef]
- Costa, D.C.S.; Gomes, M.C.; Faustino, M.A.; Neves, M.D.G.P.M.S.; Cunha, Â.; Cavaleiro, J.A.S.; Almeida, A.; Tome, J.P.C. Comparative photodynamic inactivation of antibiotic resistant bacteria by first and second generation cationic photosensitizers. Photochem. Photobiol. Sci. 2012, 11, 1905–1913. [Google Scholar] [CrossRef]
- Mlynarczyk, D.T.; Dlugaszewska, J.; Falkowski, M.; Popenda, L.; Kryjewski, M.; Szczolko, W.; Jurga, S.; Mielcarek, J.; Goslinski, T. Tribenzoporphyrazines with dendrimeric peripheral substituents and their promising photocytotoxic activity against Staphylococcus aureus. J. Photochem. Photobiol. B Biol. 2020, 204, 111803. [Google Scholar] [CrossRef]
- Wen, X.; Zhang, X.; Szewczyk, G.; El-Hussein, A.; Huang, Y.-Y.; Sarna, T.; Hamblin, M.R. Potassium Iodide Potentiates Antimicrobial Photodynamic Inactivation Mediated by Rose Bengal in In Vitro and In Vivo Studies. Antimicrob. Agents Chemother. 2017, 61, e00467-17. [Google Scholar] [CrossRef]
- Shiao, S.; Weng, S.; Luan, L.; Vicente, M.D.G.H.; Jiang, X.-J.; Ng, D.K.P.; Kolli, B.K.; Chang, K.P. Novel phthalocyanines activated by dim light for mosquito larva- and cell-inactivation with inference for their potential as broad-spectrum photodynamic insecticides. PLoS ONE 2019, 14, e0217355. [Google Scholar] [CrossRef]
- Kawczyk-Krupka, A.; Pucelik, B.; Międzybrodzka, A.; Sieroń, A.; Dąbrowski, J.M. Photodynamic therapy as an alternative to antibiotic therapy for the treatment of infected leg ulcers. Photodiagn. Photodyn. Ther. 2018, 23, 132–143. [Google Scholar] [CrossRef] [PubMed]
- Aroso, R.T.; Calvete, M.J.F.; Pucelik, B.; Dubin, G.; Arnaut, L.G.; Pereira, M.M.; Dąbrowski, J.M. Photoinactivation of microorganisms with sub-micromolar concentrations of imidazolium metallophthalocyanine salts. Eur. J. Med. Chem. 2019, 184, 111740. [Google Scholar] [CrossRef] [PubMed]
- Pucelik, B.; Sułek, A.; Drozd, A.; Stochel, G.; Pereira, M.M.; Pinto, S.M.A.; Arnaut, L.G.; Dąbrowski, J.M. Enhanced Cellular Uptake and Photodynamic Effect with Amphiphilic Fluorinated Porphyrins: The Role of Sulfoester Groups and the Nature of Reactive Oxygen Species. Int. J. Mol. Sci. 2020, 21, 2786. [Google Scholar] [CrossRef] [PubMed]
- Dlugaszewska, J.; Szczolko, W.; Koczorowski, T.; Skupin-Mrugalska, P.; Teubert, A.; Konopka, K.; Kucińska, M.; Murias, M.; Düzgüneş, N.; Mielcarek, J.; et al. Antimicrobial and anticancer photodynamic activity of a phthalocyanine photosensitizer with N -methyl morpholiniumethoxy substituents in non-peripheral positions. J. Inorg. Biochem. 2017, 172, 67–79. [Google Scholar] [CrossRef] [PubMed]
- Maisch, T. Resistance in antimicrobial photodynamic inactivation of bacteria. Photochem. Photobiol. Sci. 2015, 14, 1518–1526. [Google Scholar] [CrossRef]
- McMillin, D.R.; Shelton, A.H.; Bejune, S.A.; Fanwick, P.E.; Wall, R.K. Understanding binding interactions of cationic porphyrins with B-form DNA. Coord. Chem. Rev. 2005, 249, 1451–1459. [Google Scholar] [CrossRef]
- Arnaut, L.G. Design of porphyrin-based photosensitizers for photodynamic therapy. In Advances in Inorganic Chemistry; Elsevier: Amsterdam, The Netherlands, 2011; Volume 63, pp. 187–233. [Google Scholar] [CrossRef]
- Pucelik, B.; Arnaut, L.G.; Dąbrowski, J.M. Lipophilicity of Bacteriochlorin-Based Photosensitizers as a Determinant for PDT Optimization through the Modulation of the Inflammatory Mediators. J. Clin. Med. 2019, 9, 8. [Google Scholar] [CrossRef]
- Luz, A.F.; Pucelik, B.; Pereira, M.M.; Dąbrowski, J.M.; Arnaut, L.G. Translating phototherapeutic indices from in vitro to in vivo photodynamic therapy with bacteriochlorins. Lasers Surg. Med. 2018, 50, 451–459. [Google Scholar] [CrossRef] [PubMed]
- Maisch, T.; Baier, J.; Franz, B.; Maier, M.; Landthaler, M.; Szeimies, R.-M.; Bäumler, W. The role of singlet oxygen and oxygen concentration in photodynamic inactivation of bacteria. Proc. Natl. Acad. Sci. USA 2007, 104, 7223–7228. [Google Scholar] [CrossRef] [PubMed]
- Baier, J.; Vasold, R.; Bäumler, W.; Maisch, T.; Regensburger, J.; Loibl, M. Time dependence of singlet oxygen luminescence provides an indication of oxygen concentration during oxygen consumption. J. Biomed. Opt. 2007, 12, 064008. [Google Scholar] [CrossRef] [PubMed]
- Kourtesi, C.; Ball, A.R.; Huang, Y.-Y.; Jachak, S.M.; Vera, D.M.A.; Khondkar, P.; Gibbons, S.; Hamblin, M.R.; Tegos, G.P. Suppl 1: Microbial efflux systems and inhibitors: Approaches to drug discovery and the challenge of clinical implementation. Open Microbiol. J. 2013, 7, 34. [Google Scholar] [CrossRef]
- Tegos, G.P.; Haynes, M.; Strouse, J.J.; Khan, M.M.T.; Bologa, C.G.; Oprea, T.I.; Sklar, L.A. Microbial Efflux Pump Inhibition: Tactics and Strategies. Curr. Pharm. Des. 2011, 17, 1291–1302. [Google Scholar] [CrossRef]
- Tatsumi, R.; Wachi, M. TolC-Dependent Exclusion of Porphyrins in Escherichia coli. J. Bacteriol. 2008, 190, 6228–6233. [Google Scholar] [CrossRef]
- Grinholc, M.; Zawacka-Pankau, J.; Gwizdek-Wisniewska, A.; Bielawski, K.P. Evaluation of the Role of the Pharmacological Inhibition of Staphylococcus aureus Multidrug Resistance Pumps and the Variable Levels of the Uptake of the Sensitizer in the Strain-Dependent Response of Staphylococcus aureus to PPArg2-Based Photodynamic Ina. Photochem. Photobiol. 2010, 86, 1118–1126. [Google Scholar] [CrossRef]
- Poole, K. Efflux-Mediated Resistance to Fluoroquinolones in Gram-Positive Bacteria and the Mycobacteria. Antimicrob. Agents Chemother. 2000, 44, 2595–2599. [Google Scholar] [CrossRef]
- Nikaido, H. Multidrug resistance in bacteria. Ann. Rev. Biochem. 2009, 78, 119–146. [Google Scholar] [CrossRef]
- Rineh, A.; Dolla, N.K.; Ball, A.R.; Magana, M.; Bremner, J.B.; Hamblin, M.R.; Tegos, G.P.; Kelso, M.J. Attaching the NorA Efflux Pump Inhibitor INF55 to Methylene Blue Enhances Antimicrobial Photodynamic Inactivation of Methicillin-ResistantStaphylococcus aureus in VitroandinVivo. ACS Infect. Dis. 2017, 3, 756–766. [Google Scholar] [CrossRef]
- Tegos, G.P.; Hamblin, M.R. Phenothiazinium Antimicrobial Photosensitizers Are Substrates of Bacterial Multidrug Resistance Pumps. Antimicrob. Agents Chemother. 2006, 50, 196–203. [Google Scholar] [CrossRef] [PubMed]
- Pineiro, M.; Pereira, M.M.; Gonsalves, A.R.; Arnaut, L.G.; Formosinho, S.J. Singlet oxygen quantum yields from halogenated chlorins: Potential new photodynamic therapy agents. J. Photochem. Photobiol. A Chem. 2001, 138, 147–157. [Google Scholar] [CrossRef]
- Simões, A.V.; Adamowicz, A.; Dąbrowski, J.M.; Calvete, M.J.F.; Abreu, A.R.; Stochel, G.; Arnaut, L.G.; Pereira, M.M. Amphiphilic meso(sulfonate ester fluoroaryl)porphyrins: Refining the substituents of porphyrin derivatives for phototherapy and diagnostics. Tetrahedron 2012, 68, 8767–8772. [Google Scholar] [CrossRef]
- Monteiro, C.J.P.; Pereira, M.M.; Azenha, M.E.; Burrows, H.D.; Serpa, C.; Arnaut, L.G.; Tapia, M.J.; Sarakha, M.; Wong-Wah-Chung, P.; Navaratnam, S. A comparative study of water soluble 5,10,15,20-tetrakis(2,6-dichloro-3-sulfophenyl)porphyrin and its metal complexes as efficient sensitizers for photodegradation of phenols. Photochem. Photobiol. Sci. 2005, 4, 617–624. [Google Scholar] [CrossRef] [PubMed]
- Tuchina, E.; Tuchin, V. TiO2 nanoparticle enhanced photodynamic inhibition of pathogens. Laser Phys. Lett. 2010, 7, 607–612. [Google Scholar] [CrossRef]
- Basso, F.G.; Pansani, T.N.; Turrioni, A.P.S.; Bagnato, V.S.; Hebling, J.; Costa, C.A.D.S. In Vitro Wound Healing Improvement by Low-Level Laser Therapy Application in Cultured Gingival Fibroblasts. Int. J. Dent. 2012, 2012, 1–6. [Google Scholar] [CrossRef]
- Koti, A.; Taneja, J.; Periasamy, N. Control of coherence length and aggregate size in the J-aggregate of porphyrin. Chem. Phys. Lett. 2003, 375, 171–176. [Google Scholar] [CrossRef]
- Gonçalves, P.J.; Franzen, P.; Correa, D.S.; Almeida, L.; Takara, M.; Ito, A.; Zilio, S.; Borissevitch, I. Effects of environment on the photophysical characteristics of mesotetrakis methylpyridiniumyl porphyrin (TMPyP). Spectrochim. Acta Part A Mol. Biomol. Spectrosc. 2011, 79, 1532–1539. [Google Scholar] [CrossRef]
- Wu, D.; Huang, Y.; Hu, S.; Yi, X.; Wang, J. Sensitive Hg2+ Sensing via Quenching the Fluorescence of the Complex between Polythymine and 5,10,15,20-tetrakis(N-methyl-4-pyridyl) Porphyrin (TMPyP). Sensors 2018, 18, 3998. [Google Scholar] [CrossRef]
- Silva, E.F.F.; Serpa, C.; Dąbrowski, J.M.; Monteiro, C.J.P.; Formosinho, S.J.; Stochel, G.; Urbanska, K.; Simoes, S.; Pereira, M.M.; Arnaut, L.G. Mechanisms of Singlet-Oxygen and Superoxide-Ion Generation by Porphyrins and Bacteriochlorins and their Implications in Photodynamic Therapy. Chem. Eur. J. 2010, 16, 9273–9286. [Google Scholar] [CrossRef]
- Cui, Y.; Zeng, L.; Fang, Y.; Zhu, J.; Xu, H.-J.; Desbois, N.; Gros, C.P.; Kadish, K.M. Electrochemical and Spectroelectrochemical Properties of Free-Base Pyridyl- andN-Alkyl-4-Pyridylporphyrins in Nonaqueous Media. ChemElectroChem 2015, 3, 110–121. [Google Scholar] [CrossRef]
- Blusch, L.K. The Siamese-Twin Porphyrin and Its Copper and Nickel Complexes: A Non-Innocent Twist; Springer Science and Business Media LLC: Berlin, Germany, 2013. [Google Scholar]
- Kano, K.; Minamizono, H.; Kitae, T.; Negi, S. Self-Aggregation of Cationic Porphyrins in Water. Can π−π Stacking Interaction Overcome Electrostatic Repulsive Force? J. Phys. Chem. A 1997, 101, 6118–6124. [Google Scholar] [CrossRef]
- Egawa, Y.; Hayashida, R.; Anzai, J.-I. pH-Induced Interconversion between J-Aggregates and H-Aggregates of 5,10,15,20-Tetrakis(4-sulfonatophenyl)porphyrin in Polyelectrolyte Multilayer Films. Langmuir 2007, 23, 13146–13150. [Google Scholar] [CrossRef]
- Wilkinson, F.; Helman, W.P.; Ross, A.B. Quantum Yields for the Photosensitized Formation of the Lowest Electronically Excited Singlet State of Molecular Oxygen in Solution. J. Phys. Chem. Ref. Data 1993, 22, 113–262. [Google Scholar] [CrossRef]
- Jensen, T.J.; Vicente, M.G.H.; Luguya, R.; Norton, J.; Fronczek, F.R.; Smith, K.M. Effect of overall charge and charge distribution on cellular uptake, distribution and phototoxicity of cationic porphyrins in HEp2 cells. J. Photochem. Photobiol. B Biol. 2010, 100, 100–111. [Google Scholar] [CrossRef] [PubMed]
- Vinagreiro, C.S.; Zangirolami, A.; Schaberle, F.A.; Nunes, S.C.C.; Blanco, K.C.; Inada, N.M.; Da Silva, G.J.; Pais, A.A.C.C.; Bagnato, V.S.; Arnaut, L.G.; et al. Antibacterial Photodynamic Inactivation of Antibiotic-Resistant Bacteria and Biofilms with Nanomolar Photosensitizer Concentrations. ACS Infect. Dis. 2020, 6, 1517–1526. [Google Scholar] [CrossRef]
- Topal, S.Z.; Işci, Ü.; Kumru, U.; Atilla, D.; Gürek, A.G.; Hirel, C.; Durmuş, M.; Tommasino, J.-B.; Luneau, D.; Berber, S.; et al. Modulation of the electronic and spectroscopic properties of Zn(ii) phthalocyanines by their substitution pattern. Dalton Trans. 2014, 43, 6897–6908. [Google Scholar] [CrossRef]
- Oszajca, M.; Brindell, M.; Orzeł, Ł.; Dąbrowski, J.M.; Śpiewak, K.; Łabuz, P.; Pacia, M.; Stochel-Gaudyn, A.; Macyk, W.; Van Eldik, R.; et al. Mechanistic studies on versatile metal-assisted hydrogen peroxide activation processes for biomedical and environmental incentives. Co-ord. Chem. Rev. 2016, 327, 143–165. [Google Scholar] [CrossRef]
- George, S.; Hamblin, M.R.; Kishen, A. Uptake pathways of anionic and cationic photosensitizers into bacteria. Photochem. Photobiol. Sci. 2009, 8, 788–795. [Google Scholar] [CrossRef]
- Salmon-Divon, M.; Nitzan, Y.; Malik, Z. Mechanistic aspects of Escherichia coli photodynamic inactivation by cationic tetra-meso(N-methylpyridyl)porphine. Photochem. Photobiol. Sci. 2004, 3, 423. [Google Scholar] [CrossRef]
- Merchat, M.; Bertolini, G.; Giacomini, P.; Villaneuva, A.; Jori, G. Meso-substituted cationic porphyrins as efficient photosensitizers of gram-positive and gram-negative bacteria. J. Photochem. Photobiol. B Biol. 1996, 32, 153–157. [Google Scholar] [CrossRef]
- Valduga, G.; Breda, B.; Giacometti, G.M.; Jori, G.; Reddi, E. Photosensitization of Wild and Mutant Strains ofEscherichia colibymeso-Tetra (N-methyl-4-pyridyl)porphine. Biochem. Biophys. Res. Commun. 1999, 256, 84–88. [Google Scholar] [CrossRef] [PubMed]
- Tegos, G.P.; Masago, K.; Aziz, F.; Higginbotham, A.; Stermitz, F.R.; Hamblin, M.R. Inhibitors of Bacterial Multidrug Efflux Pumps Potentiate Antimicrobial Photoinactivation. Antimicrob. Agents Chemother. 2008, 52, 3202–3209. [Google Scholar] [CrossRef] [PubMed]
- Merchat, M.; Spikes, J.; Bertoloni, G.; Jori, G. Studies on the mechanism of bacteria photosensitization by meso-substituted cationic porphyrins. J. Photochem. Photobiol. B Biol. 1996, 35, 149–157. [Google Scholar] [CrossRef]
- Hancock, R.; Farmer, S.W.; Li, Z.S.; Poole, K. Interaction of aminoglycosides with the outer membranes and purified lipopolysaccharide and OmpF porin of Escherichia coli. Antimicrob. Agents Chemother. 1991, 35, 1309–1314. [Google Scholar] [CrossRef] [PubMed]
- Wolf, C.; Hochgräfe, F.; Kusch, H.; Albrecht, D.; Hecker, M.; Engelmann, S. Proteomic analysis of antioxidant strategies of Staphylococcus aureus: Diverse responses to different oxidants. Proteomics 2008, 8, 3139–3153. [Google Scholar] [CrossRef] [PubMed]
- Liu, Y.; Qin, R.; Zaat, S.A.J.; Breukink, E.; Heger, M. Antibacterial photodynamic therapy: Overview of a promising approach to fight antibiotic-resistant bacterial infections. J. Clin. Transl. Res. 2015, 1, 140–167. [Google Scholar] [PubMed]
- Cieplik, F.; Späth, A.; Regensburger, J.; Gollmer, A.; Tabenski, L.; Hiller, K.-A.; Bäumler, W.; Maisch, T.; Schmalz, G. Photodynamic biofilm inactivation by SAPYR—An exclusive singlet oxygen photosensitizer. Free. Radic. Biol. Med. 2013, 65, 477–487. [Google Scholar] [CrossRef]
- Maisch, T.; Spannberger, F.; Regensburger, J.; Felgenträger, A.; Bäumler, W. Fast and effective: Intense pulse light photodynamic inactivation of bacteria. J. Ind. Microbiol. Biotechnol. 2012, 39, 1013–1021. [Google Scholar] [CrossRef]
- Handzlik, J.; Matys, A.; Kieć-Kononowicz, K. Recent Advances in Multi-Drug Resistance (MDR) Efflux Pump Inhibitors of Gram-Positive Bacteria S. aureus. Antibiotics 2013, 2, 28–45. [Google Scholar] [CrossRef]
- Pinto, S.M.A.; Henriques, C.A.; Tomé, V.A.; Vinagreiro, C.S.; Calvete, M.J.F.; Dąbrowski, J.M.; Piñeiro, M.; Arnaut, L.G.; Pereira, M.M. Synthesis of meso-substituted porphyrins using sustainable chemical processes. J. Porphyrins Phthalocyanines 2016, 20, 45–60. [Google Scholar] [CrossRef]
- Liu, X.; Yeow, E.K.L.; Velate, S.; Steer, R.P. Photophysics and spectroscopy of the higher electronic states of zinc metalloporphyrins: A theoretical and experimental study. Phys. Chem. Chem. Phys. 2006, 8, 1298–1309. [Google Scholar] [CrossRef] [PubMed]
- Nguyen, K.A.; Day, P.N.; Pachter, R.; Tretiak, S.; Chernyak, V.; Mukamel, S. Analysis of Absorption Spectra of Zinc Porphyrin, Zincmeso-Tetraphenylporphyrin, and Halogenated Derivatives. J. Phys. Chem. A 2002, 106, 10285–10293. [Google Scholar] [CrossRef]
- Sułek, A.; Pucelik, B.; Kobielusz, M.; Łabuz, P.; Dubin, G.; Dąbrowski, J.M. Surface Modification of Nanocrystalline TiO2 Materials with Sulfonated Porphyrins for Visible Light Antimicrobial Therapy. Catalysts 2019, 9, 821. [Google Scholar] [CrossRef]

| Absorption | Emission | ||||||||
|---|---|---|---|---|---|---|---|---|---|
| λ (nm), ε (M−1 cm−1) 103 | λ (nm), ΦF, τF, ΦΔ | ||||||||
| Compound | B | Qy (0–1) | Qy (0–0) | Qx (0–1) | Qx (0–0) | (0–0) (0–1) | ΦF | τF/ns | Singlet Oxygen Quantum Yield |
| TPP | 418 195.3 | 513 7.9 | 549 3.4 | 590 2.2 | 645 - | 648, 714 | 0.10 | 10.1 | 0.60 |
| ClTPP | 417 234.7 | 512 15.3 | 542 4.5 | 587 3.1 | 652 - | 651, 712 | 0.04 | 7.2 | 0.65 |
| Cl2TPP | 418 258.6 | 511 15.3 | 541 - | 588 - | 657 - | 649, 714 | 0.02 | 4.9 | 0.83 |
| TPPS | 420 205.3 | 515 8.6 | 550 6.9 | 590 - | 646 - | 650, 715 | 0.10 | 11.5 | 0.70 |
| Cl2TPPS | 419 240.5 | 513 17.0 | 544 5.3 | 587 3.4 | 642 2.7 | 648, 711 | 0.02 | 6.0 | 0.95 |
| TMPyP | 425 190.3 | 521 6.9 | 585 1.9 | 640 | 664, 714 | 0.05 * | 4.6 ** | 0.70 | |
| TPP | ClTPP | Cl2TPP | TPPS | Cl2TPPS | TMPyP | |
|---|---|---|---|---|---|---|
| ∆ES1-T1 | 0.75 | 0.78 | 0.78 | 0.75 | 0.79 | 0.70 |
| ∆ES1-T2 | 0.52 | 0.49 | 0.47 | 0.51 | 0.48 | 0.43 |
| ∆ES3-T1 | 1.70 | 1.71 | 1.69 | 1.68 | 1.70 | 1.51 |
| ∆ES3-T2 | 1.47 | 1.42 | 1.39 | 1.44 | 1.40 | 1.24 |
| Compound | LogP |
|---|---|
| TPP | 3.02 |
| ClTPP | 3.09 |
| Cl2TPP | 3.12 |
| TPPS | −1.20 |
| Cl2TPPS | −1.08 |
| TMPyP | 2.06 |
Publisher’s Note: MDPI stays neutral with regard to jurisdictional claims in published maps and institutional affiliations. |
© 2020 by the authors. Licensee MDPI, Basel, Switzerland. This article is an open access article distributed under the terms and conditions of the Creative Commons Attribution (CC BY) license (http://creativecommons.org/licenses/by/4.0/).
Share and Cite
Sułek, A.; Pucelik, B.; Kobielusz, M.; Barzowska, A.; Dąbrowski, J.M. Photodynamic Inactivation of Bacteria with Porphyrin Derivatives: Effect of Charge, Lipophilicity, ROS Generation, and Cellular Uptake on Their Biological Activity In Vitro. Int. J. Mol. Sci. 2020, 21, 8716. https://doi.org/10.3390/ijms21228716
Sułek A, Pucelik B, Kobielusz M, Barzowska A, Dąbrowski JM. Photodynamic Inactivation of Bacteria with Porphyrin Derivatives: Effect of Charge, Lipophilicity, ROS Generation, and Cellular Uptake on Their Biological Activity In Vitro. International Journal of Molecular Sciences. 2020; 21(22):8716. https://doi.org/10.3390/ijms21228716
Chicago/Turabian StyleSułek, Adam, Barbara Pucelik, Marcin Kobielusz, Agata Barzowska, and Janusz M. Dąbrowski. 2020. "Photodynamic Inactivation of Bacteria with Porphyrin Derivatives: Effect of Charge, Lipophilicity, ROS Generation, and Cellular Uptake on Their Biological Activity In Vitro" International Journal of Molecular Sciences 21, no. 22: 8716. https://doi.org/10.3390/ijms21228716
APA StyleSułek, A., Pucelik, B., Kobielusz, M., Barzowska, A., & Dąbrowski, J. M. (2020). Photodynamic Inactivation of Bacteria with Porphyrin Derivatives: Effect of Charge, Lipophilicity, ROS Generation, and Cellular Uptake on Their Biological Activity In Vitro. International Journal of Molecular Sciences, 21(22), 8716. https://doi.org/10.3390/ijms21228716

